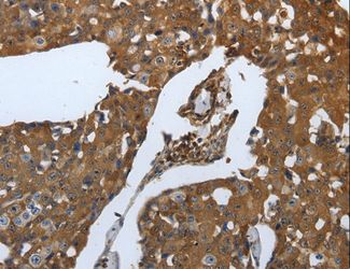
SLC34A2/NaPi-2b Antibody

You have no items in your shopping cart.
- Featured
NPT2b rabbit pAb Antibody [orb766709]Featured
ELISA, WB
Human, Rat
Polyclonal
Unconjugated
100 μl, 50 μl - Featured
ActiveFeatured
ActiveGreater than 90% as determined by SDS-PAGE.
45.5 kDa
Mammalian cell
1 mg, 100 μg, 20 μg FC, Kinetics
Human
Monoclonal
Unconjugated
100 μg- NaPi2b / SLC34A2 Reference Antibody (Lifastuzumab) [orb1817848]
FC, Kinetics
Human
Monoclonal
Unconjugated
100 μg - Featured
Human SLC34A2 protein [orb419212]Featured
Greater than 85% as determined by SDS-PAGE.
27.1 kDa
E.coli
20 μg, 100 μg, 1 mg